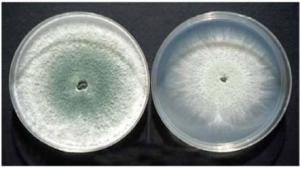
Hongos benéficos controlan patógenos y promueven crecimiento

biorracional/orgánico

Biológicos22 de febrer, 2012
Mantén la sanidad de tus cultivos con microorganismos
Biológicos18 de enero, 2012
Agrinos, empresa enfocada a la investigación y desarrollo...

Biológicos11 de enero, 2012
Remedia tus problemas de Mosca blanca

Biológicos11 de noviembre, 2011
Consumo orgánico en México
Biológicos4 de noviembre, 2011
Seipasa presenta 3 líneas de productos en Expo Agroalimen...

Biológicos4 de noviembre, 2011